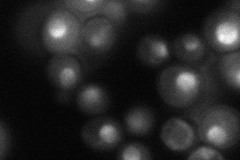
YGR081C
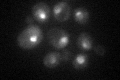
YGR081C

View description
Protein required for pre-rRNA processing; associated with the 90S pre-ribosome and 43S small ribosomal subunit precursor; interacts with U3 snoRNA; deletion mutant has synthetic fitness defect with an sgs1 deletion mutant
Localization:
Intensity:
Fold change:
Significance:
-
C’ GFP library in SD

nucleus61.76 -
N' NOP1pr-GFP in SD

nucleus,nucleolus74.7733 -
N' TEF2pr-mCherry in SD

nucleus23.9897 -
N' NATIVEpr-GFP in SD
nucleus,nucleolus50.9273 -
N' TEF2pr-VC and Cyto-VN in SD

#N/A0 -
C’ GFP library in SD+DTT

nucleus42.190.68No -
C’ GFP library in SD+H2O2
nucleus43.910.71No -
C’ GFP library in Starvation Media

punctateN/AN/AYes -
C’ GFP library on the background of Pup2-DaMP

nucleus -
C’ GFP library on the background of CCT mutant

nucleus54.83910.88786No
